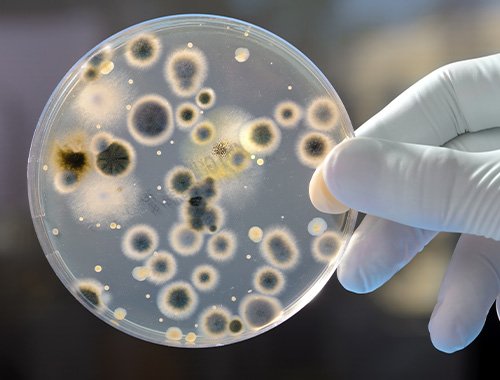
UOSD Microbiology and Virology

DEPARTMENTS OF CLINICAL AND DERMATOLOGICAL RESEARCH
UOC

UOC Clinical Dermatology

UOC Skin Physiopathology Laboratory
UOSD

UOSD Dermatologic Oncology

UOSD Sexually Transmitted Diseases, Allergology, Migration Medicine and Tropical Diseases

UOSD Plastic and Reconstructive Surgery

UOSD Porphyria and Rare Diseases

UOSD Radiology ISG

UOSD Genetic Research Molecular Biology and Dermatophatology
UOSD Microbiology and Virology




